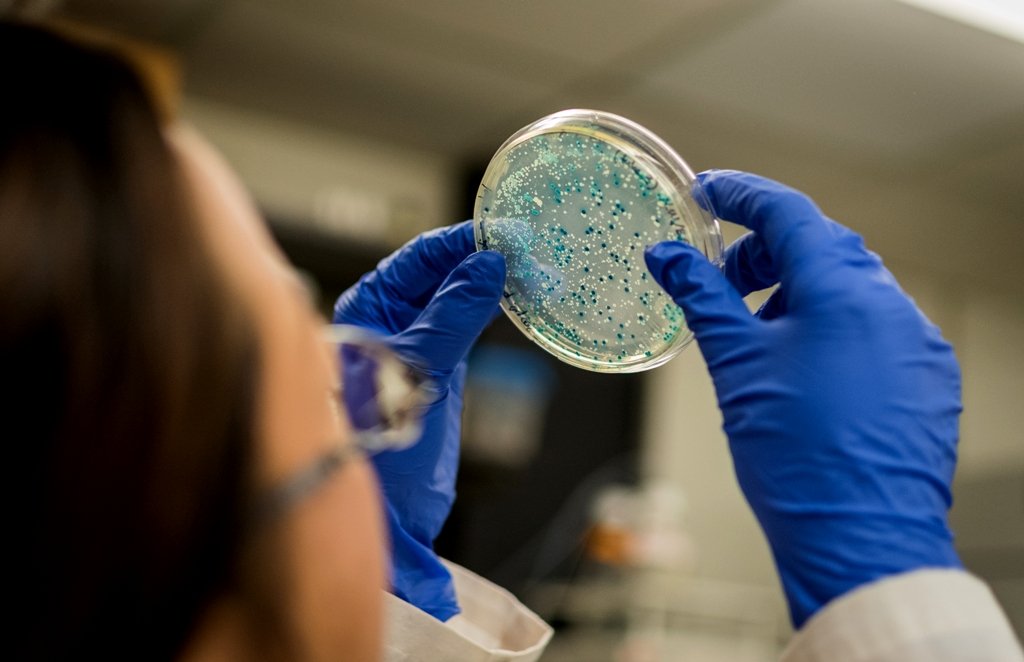

ANPII Bio, única associação 100% dedicada à indústria de bioinsumos a integrar formalmente o Grupo de Trabalho (GT) do MAPA, defende um marco legal que reduza a burocracia, garanta a coexistência entre produção industrial e on farm, reconheça a multifuncionalidade e que estimule o redirecionamento de recursos de exigências regulatórias para pesquisa e inovação
Sancionada em dezembro de 2024, a Lei dos Bioinsumos (Lei nº 15.070) abriu um novo capítulo para a agricultura sustentável no Brasil, mas sua efetividade depende da regulamentação – atualmente em elaboração por meio de um Grupo de Trabalho (GT) instituído pelo Ministério da Agricultura e Pecuária (MAPA).
Única entidade da indústria dedicada exclusivamente aos bioinsumos a integrar formalmente o GT do MAPA, a ANPII Bio (Associação Nacional de Promoção e Inovação da Indústria de Biológicos) atua para garantir que o marco legal seja estruturado em pilares que conciliem rigor técnico, segurança e estímulo à inovação.
Para isso, defende uma regulamentação baseada em ciência e risco proporcional, que reduza burocracias e agilize o acesso de novos produtos ao mercado, além do reconhecimento da multifuncionalidade dos bioinsumos, controle de qualidade adaptado à natureza de cada produto, fiscalização equilibrada e incentivos fiscais e tributários para fortalecer a indústria nacional.
Por meio de um arcabouço regulatório claro e moderno, sustenta que o país se aproxima das melhores práticas internacionais, fortalece a competividade da indústria nacional e acelera a expansão do setor, que movimentou R$ 5,7 bilhões na última safra e deve crescer 60% até o fim da década.

O principal desafio neste momento é criar um regulamento que facilite e amplie a adoção dos bioinsumos pelos agricultores Foto Divulgação
Competitividade do setor
Júlia Emanuela de Souza, diretora de relações institucionais da ANPII Bio, afirma que é fundamental que os recursos sejam aplicados em pesquisa, expansão tecnológica e comercialização, e que a produção industrial e on-farm (produção de bioinsumos nas propriedades rurais), possam coexistir de forma ordenada e supervisionada, fortalecendo a competitividade do setor. “Além disso, os incentivos fiscais previstos pela lei são fundamentais para atrair investimentos e fomentar a pesquisa. Essa é a chave para ganharmos escala e competitividade, posicionando as empresas brasileiras de bioinsumos na liderança global deste mercado”, ressalta.
Na avaliação de Marcus Coelho, que está à frente da Coordenação de Bioinsumos e Novas Tecnologias do Departamento de Apoio à Inovação para Agropecuária (CORBIO/DIAGRO) do MAPA, o principal desafio neste momento é criar um regulamento que facilite e amplie a adoção dos bioinsumos pelos agricultores. “Com o aumento da demanda, o setor poderá se consolidar, mas surgem novos pontos de atenção: a necessidade de inovação constante, a oferta de produtos seguros, eficazes e de qualidade, e a ampliação da capacitação técnica e do acesso a informações qualificadas sobre produção e uso desses insumos”, destaca.
LEIA TAMBÉM

Bioinsumos são produtos naturais derivados de microrganismos, plantas, animais e outros compostos orgânicos, com modos de ação complexos que muitas vezes combinam diferentes funções agronômicas Foto Divulgação
Atuação no processo regulatório
Coelho reforça que, em 2024, a ANPII Bio teve papel decisivo na aprovação da Lei dos Bioinsumos. “Atualmente, como integrante do GT do MAPA, concentra seus esforços na elaboração de uma proposta de regulamentação ancorada em três eixos principais: especialização técnica setorial, representatividade da cadeia produtiva completa e abordagem proativa no diálogo com o poder público”, informa.
Ele complementa que, “com foco exclusivo em bioinsumos, representa desde startups de base tecnológica até empresas internacionais de grande porte, reunindo experiência que vai da microbiologia aplicada às regras de registro de diferentes categorias, incluindo insumos biológicos para uso animal – uma área ainda em expansão que exige conhecimento especializado.”
O coordenador do CORBIO/DIAGRO do MAPA sublinha que o trabalho da entidade se concretiza na elaboração de minutas de normativas, notas técnicas e estudos de impacto encaminhados ao poder público, aliado ao diálogo direto com MAPA, ANVISA e IBAMA, a fim de propor normas viáveis e baseadas em evidências.
“A ANPII Bio tem trazido importantes contribuições técnicas, com destaque nas discussões sobre bioinsumos para a pecuária. A decisão do MAPA de envolver as entidades tem se mostrado acertada, considerando a diversidade dos bioinsumos e o trabalho de identificação e categorização detalhada dessas tecnologias, em que o conhecimento prático das associações é essencial para garantir clareza e aplicabilidade ao marco regulatório”, avalia Coelho.

Os bioinseticidas controlam doenças e pragas nas lavouras, como a Lagarta-do-cartucho-do-milho Foto Marina-Pessoa/Embrapa/Divulgação
Eixos estratégicos
Dentre os eixos estratégicos que a entidade defende, está uma regulamentação baseada em ciência e risco proporcional, evitando exigências genéricas que atrasam o avanço tecnológico sem trazer ganhos efetivos em confiabilidade. Além disso, propõe a aceitação de dados internacionais quando compatíveis e a criação de regras que reconheçam a flexibilidade dos bioinsumos, tanto no registro de produtos quanto na validação de metodologias desenvolvidas por especialistas.
Com isso, articula para que o ambiente regulatório seja inovador e seguro para produtores, consumidores e meio ambiente. No campo de avaliação toxicológica, por exemplo, a entidade reforça o alinhamento com os critérios da ANVISA, que preconiza dossiês técnicos e análises baseadas em normas internacionais de padronização e rotulagem, garantindo que os riscos sejam claros e compreensíveis – um princípio basilar da avaliação da segurança à saúde humana, que se dá por meio da caracterização e classificação do perigo.
LEIA TAMBÉM
Demandas do setor produtivo
Marina de Aguiar, responsável pela Gerência de Avaliação de Segurança Toxicológica (Geast), unidade vinculada à Gerência Geral de Toxicologia (GGTOX) da Agência Nacional de Vigilância Sanitária (ANVISA), reforça que a atuação da ANPII Bio tem sido relevante ao organizar e apresentar de forma estruturada as demandas do setor produtivo. “Considerando que os bioinsumos fitossanitários possuem processos produtivos complexos e suscetíveis a variações biológicas, essas medidas são indispensáveis. Por meio da participação colaborativa, o marco legal deve ser guiado por critérios técnicos que aliem segurança, incentivo à inovação e previsibilidade ao setor”, sustenta.
Outro eixo defendido é o reconhecimento da multifuncionalidade dos produtos biológicos, permitindo registros únicos para bioinsumos com diferentes funções agronômicas.

Com o aumento da demanda, surgem a necessidade de inovação constante, a oferta de produtos seguros, eficazes e de qualidade, e a ampliação da capacitação técnica e do acesso a informações qualificadas sobre produção e uso desses insumos
Foto Divulgação
Controle de qualidade
Júlia Emanuela de Souza argumenta ainda que “quanto ao controle de qualidade, ele deve ser adaptado às especificidades da produção industrial e da produção on-farm, esta última com protocolos simplificados, mas que respeitem critérios mínimos, como presença de responsável técnico e regras claras para uso próprio”.
Complementarmente, defende proteção jurídica e previsibilidade regulatória, com registros de validade indeterminada desvinculados da marca comercial, além de uma legislação que fortaleça a produção nacional, a competitividade e novas tecnologias, por meio de incentivos fiscais, proteção de dados por dez anos e retorno sobre investimentos em Pesquisa & Desenvolvimento (P&D).
“Por meio desses pilares, não queremos criar barreiras, mas abrir caminhos: para produtores, agrônomos e consultores, distribuidores e, acima de tudo, para a sociedade, que se beneficia de alimentos mais seguros, saudáveis e sustentáveis. Nosso objetivo é que os bioinsumos sejam reconhecidos como soluções confiáveis, acessíveis e transformadoras para toda a cadeia”, continua a porta-voz da ANPII Bio.

A “revolução dos bioinsumos” tem transformado a agricultura brasileira trazendo mais sustentabilidade, produtividade e inovação ao campo
Foto Divulgação
LEIA TAMBÉM
Delegação da SNA e SNASH visita empresa líder em industrialização agrícola orgânica na China
Produtos multifuncionais
Ela explica que os bioinsumos são produtos naturais derivados de microrganismos, plantas, animais e outros compostos orgânicos, com modos de ação complexos que muitas vezes combinam diferentes funções agronômicas. Um mesmo microrganismo, por exemplo, pode atuar como bioestimulante, aumentando a resistência a estresses abióticos, e como biodefensivo, controlando pragas e doenças.
“Essa multifuncionalidade permite que um único produto impacte a planta de várias formas simultaneamente. Sem uma legislação que permita o registro único para produtos multifuncionais, as empresas podem ser obrigadas a registrar cada função separadamente – o que gera burocracia, custos e atrasos no acesso ao mercado, sem ganhos reais de segurança”, avalia Júlia Emanuela.
E complementa: “Por isso, desde que o bioinsumo comprove eficácia e mantenha rastreabilidade e controle de qualidade, defendemos o registro único. Para os produtores, isso significa acesso mais rápido a soluções completas, eficientes e de menor custo operacional. Esses produtos são, ao mesmo tempo, um diferencial e um desafio regulatório: bem regulados, impulsionam crescimento e desenvolvimento; mal regulados, viram entraves. Por isso, esse é um ponto essencial da regulamentação”, ressalta.
Um mesmo microrganismo pode atuar como bioestimulante, aumentando a resistência a estresses abióticos, e como biodefensivo, controlando pragas e doenças Foto ANPII Bio/Divulgação
Controle de qualidade e produção on-farm
De acordo com avaliação de Júlia, o controle de qualidade é outro pilar crítico. “A ANPII Bio defende que as exigências sejam proporcionais ao risco e adaptadas a cada tipo de produto, diferenciadas por ativo, como microrganismo, macrorganismo ou substância, e que metodologias alternativas validadas pelas empresas sejam aceitas quando não houver método oficial”, reforça.
Ela informa também que, para a produção industrial, a entidade defende rastreabilidade total e controle de lote. Já em biofábricas que manipulam ativos não microbianos ou comunidades microbianas de povos e comunidades tradicionais, com histórico seguro de uso, propõe regras que não exijam equipamentos complexos, cujo custo inviabilizaria atividades de baixo risco.
A diretora de relações institucionais da ANPII Bio, destaca que, na produção on-farm, a entidade defende protocolos simplificados, mas com critérios básicos de qualidade e segurança. “Isso inclui o uso de cepas rastreáveis de bancos de germoplasma credenciados pelo MAPA, inóculos comerciais já registrados ou microrganismos constantes em uma lista positiva previamente aprovada pelo órgão, além da presença de responsável técnico e normas para transporte e armazenamento, garantindo qualidade microbiológica e evitando contaminações”, sublinha.
Na avaliação da porta-voz da ANPII Bio, o modelo deve ser restrito ao uso próprio, sem comercialização, para preservar padrões de qualidade e direitos de propriedade intelectual.
“Acreditamos que a produção on-farm pode coexistir com a industrial, desde que limitada ao uso próprio e supervisionada tecnicamente. Incentivamos pequenos produtores a se organizarem em cooperativas, compartilhando responsável técnico e infraestrutura, a fim de viabilizar a produção em conformidade com a regulamentação”, explica.
LEIA TAMBÉM
Controle biológico evita perdas de R$ 4,3 milhões na cultura da erva-mate

Júlia Emanuela: “Nosso futuro biológico começa hoje” Foto ANPII Bio/Divulgação
Um marco para a agricultura sustentável
Marcus Coelho, coordenador do CORBIO/DIAGRO do MAPA, sustenta que a chamada “revolução dos bioinsumos” tem transformado a agricultura brasileira, trazendo mais sustentabilidade, produtividade e inovação ao campo. Nesse cenário, a aprovação da Lei dos Bioinsumos foi um marco essencial, criando as bases para um setor mais moderno, estruturado e seguro.
Ele informa que, atualmente, além dos esforços para a regulamentação, o MAPA atua de forma consistente para estimular a inovação aberta no setor, com atenção especial às startups e pequenos negócios, fortalecendo a geração de soluções e a competitividade da indústria nacional.
“A criação da Rede de Inovação em Bioinsumos (RIB), que articula universidades, centros de pesquisa, indústria, governo e sociedade civil, tem acelerado a geração de novas soluções e fortalecido os agentes envolvidos. Essa integração é fundamental para atrair investimentos de longo prazo e consolidar o Brasil como referência global nesta nova economia”, reforça Coelho.
Momento histórico
Para a ANPII Bio, o momento é histórico. “No âmbito do marco legal, é preciso unir esforços para que essas novas regras avancem de forma eficaz, desburocratizando sem abrir mão da confiabilidade e estimulando a modernização do setor, com uma legislação construída pelo campo, para o campo. Nosso futuro biológico começa hoje”, avalia Júlia Emanuela, diretora de relações institucionais da entidade.
Starups de Bioinsumos do SNASH
ByMyCell
Leia matéria completa em
Decoy Smart
Leia matéria completa em
Biotech B4A
Leia matéria completa em
Tolveg
Leia matéria completa em
Entomotec
Leia matéria completa em